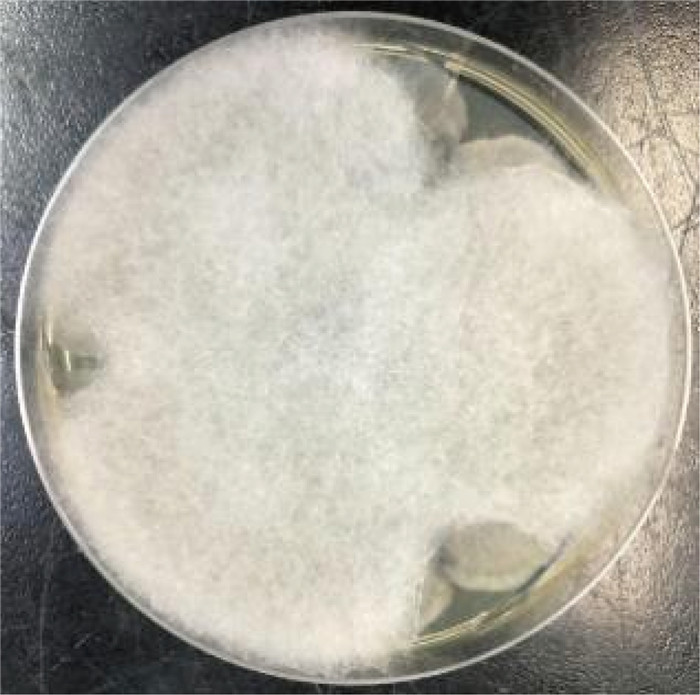

毛霉菌病是由毛霉目真菌各种成员引起的感染性疾病。毛霉菌感染为一种少见的机会性感染,好发于免疫低下人群,该病起病急、进展快、临床表现不典型,缺乏特征性的影像学改变及特异的实验室指标,培养阳性率低,早期诊断困难,病死率高[1]。多数血液系统疾病患者,因其自身疾病因素、化疗、骨髓移植而免疫力低下,加之治疗期间广谱抗生素的应用,致使近年来毛霉菌感染患者的数量有所上升。毛霉菌病好侵袭血管,沿血管壁发育并穿过血管壁,导致内皮细胞破坏和局部血栓形成,组织坏死[2]。毛霉菌病最常见的临床类型为鼻眶脑型、肺型、皮肤型和播散型,占比分别为34%、21%、20%和14%[3],患者病死率高,治疗难度大,及早明确诊断、及时联合治疗有助于降低病死率,提高疗效。本文报告1例儿童急性淋巴细胞白血病(acute lymphoblastic leukemia,ALL)诱导化疗期间合并鼻眶脑型毛霉菌病的诊治经过。
1 临床资料 1.1 入院情况患者为3岁女童,主因“间断发热、发现两系减低1月余”,经急诊收入邢台市人民医院小儿血液肿瘤科。入院后化验血常规,结果如下:白细胞2.62×109/L,血红蛋白:75 g/L,红细胞:2.81×1012/L,血小板:105×109/L,中性粒细胞绝对值0.14×109/L。末梢血分类: 幼稚细胞2%。完善骨髓象:考虑急性淋巴细胞白血病。骨髓流式细胞报告单:符合B-ALL免疫表型,普通B细胞型(common-B-ALL)。白血病融合基因:阴性,染色体:55XX,+X,+4,+8,+10,+14,+17,+18,+21,+21[6]/46, XX[2]。结合骨髓白血病形态学-免疫学-细胞遗传学-分子生物学(morphology-immunology-cytogenetics-molecular,MICM)分型检查,确诊为急性B淋巴细胞性白血病。
1.2 化疗经过依照中国儿童白血病协作组(Chinese Children’s Leukemia Group,CCLG)2008方案化疗。予泼尼松口服诱导治疗1周,第8天查外周血幼稚细胞数 < 1 000/μL,期间行腰椎穿刺术检查脑脊液均未见白血病细胞,行静脉联合化疗(共用长春地辛3 mg/m2×4次,柔红霉素30 mg/m2×3次,因感染暂停一次,培门冬酶2 500 IU/m2 ×2次,地塞米松6 mg/m2×3周,第4周开始减量,每3天减半量,9天减完)。化疗第15天及第33天复查骨髓象提示缓解,骨髓微小残留病灶(minimal residual disease,MRD) < 0.01 %,结合临床考虑骨髓达到完全缓解状态。
1.3 病情变化及预后患儿入院即存在中性粒细胞缺乏伴发热,感染控制后予以诱导缓解治疗(VDLD):长春新碱(vincristine)+柔红霉素(daunorubicin)+培门冬(pegaspargase)+地塞米松(dexamethasone)。患儿第13天再次出现发热,多次调整抗感染方案,先后曾给予美洛培南、万古霉素、伏立康唑、卡泊芬净、两性霉素B等抗感染治疗,体温控制欠佳,无热期1~2天,C反应蛋白(C-reactive protein,CRP)最高升至216 mg/L,降钙素原为2.27 ng/mL。期间多次完善胸部计算机断层扫描(computed tomography,CT)、腹部超声,均未提示明确异常。血培养、骨髓培养、脑脊液培养提示无菌生长,1,3-β-D葡聚糖抗原检测及半乳甘露聚糖抗原检测试验(G/GM试验)结果为阴性。VDLD诱导缓解治疗第19天患儿诉上门齿疼痛,经口腔科会诊及颌面部超声检查未提示明显异常,VDLD治疗第30天患儿出现左侧眼睑肿胀,伴有少量分泌物,给予妥布霉素滴眼液滴眼。VDLD诱导缓解治疗完成后第2天,患儿出现右侧鼻出血,左侧鼻腔流涕,且伴有喉中痰鸣,完善痰培养,并于耳鼻喉科行鼻腔镜检查,镜下双侧鼻腔可见血痂、干酪样物质,右侧中鼻甲、鼻中隔黏膜糜烂、吸收、缺如,骨质裸露、部分缺损,中鼻道霉菌团块,后鼻孔见坏死性干痂(见图 1),鼻腔分泌物行涂片检查: 找到真菌无隔菌丝(见图 2),分泌物及痰培养提示霉菌生长(见图 3)。急查头颅CT,见左侧颞叶低密度。行头颅磁共振成像(magnetic resonance imaging,MRI)平扫+增强,提示:左侧颞叶多发异常信号,右侧基底节区及左侧颞叶多发弥散受限灶,右侧颞叶病变内强化灶;蝶窦、左侧鼻腔、左侧上额窦、筛窦信号增高,结构欠清,前额部部分软脑膜明显强化,结合患者的病史,考虑真菌感染可能性大(见图 4)。患儿发热期间曾给予两性霉素B静滴,终因肾功能损害及低钾血症而暂停应用。患儿鼻眶脑型毛霉菌病诊断明确后立即给予两性霉素B脂质体(锋克松)静点,初始剂量0.5 mg/kg/d,逐渐增至2.5 mg/kg/d维持,同时予泊沙康唑90 mg/次,一日4次口服;期间给予两性霉素B雾化及鞘内注射,鞘内注射初始剂量为0.1 mg,逐渐增加至最大1 mg,每周2~3次,出院前共鞘注7次,两性霉素B总量为3.55 mg,期间因患儿头痛、血压高而减少鞘注剂量。患儿在接受两性霉素B脂质体抗真菌治疗期间出现肾功能损害及低血钾,予以调整两性霉素B脂质体剂量及静脉补钾治疗。应用两性霉素B脂质体抗真菌治疗后患儿热峰降低,C反应蛋白降至15 mg/L,左侧眼睑肿胀减轻,精神状态较之前明显好转,但患儿出现左侧上睑下垂,左眼球活动障碍,双侧瞳孔不等大,视物不清,复查头颅磁共振增强扫描,提示:脑内多发异常信号,右侧基底节区病变略缩小,余病变较前增大(见图 5), 建议家属待患儿血象恢复后手术切除感染灶,家属要求出院,院外继续口服泊沙康唑,未行手术及化疗,半年后死于白血病复发。

|
| 图 1 鼻腔镜检查 Fig. 1 Nasal endoscopy examination |

|
| A:乳酸酚棉蓝染色:目镜×10,油镜×100;B:革兰氏染色:目镜×10,油镜×100。 A: Latic acid phenol cotton blue staining: eyepiece ×10, oil immersion lens×100; B: Gram staining: eyepiece ×10, oil immersion lens×100. 图 2 分泌物涂片检查 Fig. 2 Smear examination of secretions |
|
| 图 3 分泌物培养可见霉菌 Fig. 3 Visible mold in secretion culture |

|
| Red arrow: Signal abnormality. 图 4 头颅磁共振增强扫描 Fig. 4 Brain enhanced magnetic resonance imaging |

|
| Red arrow: Signal abnormality. 图 5 头颅磁共振增强扫描复查 Fig. 5 Reexamination of brain enhanced magnetic resonance imaging |
毛霉菌是一种无处不在的真菌,通常存在于土壤、腐烂的有机物、堆肥和被污染的食物中,是一种需氧菌,由黑色的球形孢子和白色管状的菌丝构成,其所导致的毛霉菌病是除了曲霉病和念珠菌病外,位列第3的侵袭性真菌感染疾病[4]。在免疫功能低下的患者中发病率较高,特别是糖尿病患者、正在接受化疗或免疫治疗的患者、实体器官和造血干细胞移植患者、恶性血液病患者和长期使用皮质类固醇治疗的患者。恶性血液病,特别是长期中性粒细胞减少的患者和造血干细胞移植受者,感染概率似乎高于实体器官移植受者[5]。毛霉菌可引起各种形式的感染,包括皮肤软组织感染、鼻眶脑型感染、肺感染、胃肠道感染、播散感染和其他罕见形式,当2个或者2个以上不连续部位感染时,可认为是毛霉菌病播散性感染。毛霉菌病的症状类似于曲霉菌病、念珠菌病或与其他疾病并存的感染,且没有特异性的检测,导致其诊断很困难,迄今为止,仍没有可准确评估毛霉菌病的独立诊断实验。毛霉菌病的诊断主要依靠患者特殊的基础性疾病,并根据其临床表现、抗生素的疗效、病变部位标本真菌镜检及培养,活检发现特征性菌丝和病理改变等来确诊,冰冻切片和内镜检查可作为早期诊断的方法,但确诊还需要组织学依据。近期有报道称,采用宏基因组非一代测序(metagenomics next generation sequencing,mNGS)快速检出毛霉菌[6]可增加确诊几率。近年来虽然毛霉菌病在诊断和治疗方面都取得了显著进展,但毛霉菌的死亡率仍很高,尤其是在恶性血液病和接受造血干细胞移植的患者中,毛霉菌的死亡率取决于感染的种类、患者的医疗状况以及治病真菌种类。毛霉菌病在鼻窦感染的患者中死亡率为46%,肺部感染患者中的死亡率为76%,脑型毛霉菌病的死亡率接近80%,播散性毛霉菌病的死亡率达到96%[7]。
本例患者的基础疾病为急性淋巴细胞白血病,诱导缓解治疗期间,患者反复高热,多次完善病原学检查、胸部CT、腹部超声及G/GM实验等,均未提示有明确的病原学感染及感染灶。后患儿出现眼睑肿胀、鼻出血,进而完善鼻腔镜及头颅核磁,发现感染灶,经鼻腔分泌物培养提示存在毛霉菌感染,累及鼻腔、左侧眼眶、眼部及颅内,鼻腔受累坏死组织成黑色焦痂,左侧颞叶、前额部分脑膜多发真菌感染灶,右侧基底节区及左侧颞叶存在急性-亚急性期脑梗死,遂确诊为鼻眶脑型毛霉菌感染。鼻眶脑型毛霉菌感染多由吸入空气中的毛霉菌孢子而引发,毛霉菌具有强烈的侵袭性,在感染部位菌丝可直接或者通过血液侵袭周围组织。通常先累及口腔、牙齿、上额窦,后侵及余鼻窦、颅底、眼眶和颅内,在感染部位形成黑色焦痂,菌丝容易侵袭颈动脉及小动脉,临床表现为不同部位组织的血管栓塞、组织坏死[8]。鼻眶脑型毛霉菌病早期预警体征包括面部疼痛、鼻塞、鼻腔血性或棕黑色分泌物,上额窦、筛窦受累时可出现面部麻木或水肿,上腭受累可表现为上腭溃疡,也可表现为牙痛或上颌牙松动和颌骨活动受限,侵入眼部后,可出现视力模糊或复视、眼窝疼痛、感觉异常或眼球突出,眶尖综合征表现,受累部位可见焦痂,侵及脑部可表现为脑水肿、血管侵犯,可导致脑梗死[9]。
恶性血液病合并毛霉菌病需要联合治疗,包括手术、抗真菌治疗和控制潜在易感因素。手术治疗和两性霉素B制剂应用是治疗毛霉菌病的一线治疗方法,早期积极的手术切除以及对受影响组织的清创对于局部控制毛霉菌病是必要的,但是恶性血液病患者往往无法耐受根治性的清创手术。以“急性淋巴细胞白血病和毛霉菌”“acute lymphoblastic leukemia和mucormycosis”为检索词分别在万方、PubMed上检索近10年的相关文献,共检索出中文文献14篇,英文文献90篇。剔除年龄大于18岁及重复病例,共收集到与本文病例相似的中文报道4篇[10-13],英文报道12[14-25]篇,共有病例17例,其中鼻眶脑型8例,毛霉菌侵及颅内6例,截至文献收录时死亡病例共5例,均为毛霉菌侵及颅内病例。治疗上选择药物+手术切除、清创的共12例,单纯药物治疗的有5例,治疗药物以静脉应用两性霉素B脂质体+口服泊沙康唑为主(见表 1)。
| 参考文献 | 例数 | 基础疾病 | 发生时期 | 伏立康唑用药史 | 年龄(岁)/性别 | 毛霉菌类型 | 治疗药物 | 是否累及中枢 | 是否手术 | 预后 |
| 郑洪等[10] | 1 | ALL | 不详 | 不详 | 不详 | 鼻眶肺型 | 两性霉素B | 否 | 是 | 存活 |
| 高陆等[11] | 1 | T-ALL | 诱导化疗 | 否 | 14/男 | 鼻眼脑型 | 两性霉素B脂质体+泊沙康唑+两性霉素B鞘注 | 是 | 是 | 口服泊沙康唑维持 |
| 李文梓等[12] | 1 | ALL | 不详 | 不详 | 11/女 | 肺脑型 | 两性霉素B脂质体+泊沙康唑 | 是 | 否 | 死亡 |
| 霍春秀等[13] | 1 | T-ALL | 诱导化疗 | 是 | 8 /男 | 鼻脑型 | 两性霉素B脂质体+泊沙康唑 | 是 | 否 | 死亡 |
| Damavandi等[14] | 1 | B-ALL | 复发化疗 | 否 | 12/女 | 脑型 | 两性霉素B+卡泊芬净 | 是 | 是 | 泊沙康唑维持 |
| Rincón等[15] | 1 | B-ALL | 化疗2月 | 否 | 12/男 | 鼻眶 | 泊沙康唑+两性霉素B脂质体 | 颅底 | 是 | 泊沙康唑+两性霉素B脂质体维持 |
| Kebudi等[16] | 1 | Pre- B-ALL |
延迟强化治疗 | 是 | 8/男 | 鼻眶 | 两性霉素B脂质体 | 无 | 是 | 泊沙康唑维持 |
| Sharifpour等[17] | 1 | ALL | 复发再次诱导化疗 | 是 | 18/男 | 鼻脑 | 两性霉素B脂质体+泊沙康唑 | 是 | 是 | 死亡 |
| Dworsky等[18] | 1 | Pre- B-ALL |
复发后再诱导化疗 | 无 | 17/女 | 鼻脑、 肺(继发) |
两性霉素B脂质体+泊沙康唑、米卡芬净+ommaya囊鞘内注射两性霉素B | 是 | 是 | 好转 |
| Ojeda- Diezbarroso等[19] |
1 | ALL/类固醇继发糖尿病 | 巩固化疗 | 无 | 12/女 | 鼻眶脑 | 两性霉素B/两性霉素B脂质体+泊沙康唑 | 是 | 是 | 泊沙康唑维持治疗后好转 |
| Jensen等[20] | 1 | Pre- B-ALL |
诱导化疗 | 是 | 3/女 | 鼻眶脑 | 两性霉素B脂质体+泊沙康唑+特比奈芬+ommaya囊鞘内注射两性霉素B | 是 | 是 | 治愈 |
| Barg等[21] | 2 | ALL | 化疗6个月 | 不详 | 4/男 | 鼻眶脑 | 两性霉素B+艾沙康唑 | 是 | 是 | 艾沙康唑维持好转 |
| ALL | 巩固化疗 | 不详 | 5/男 | 鼻脑 | 两性霉素B+艾沙康唑 | 是 | 否 | 艾沙康唑维持好转 | ||
| Altini等[22] | 1 | ALL | 不详 | 不详 | 13/女 | 鼻眶脑 | 两性霉素B脂质体,因AmB肾毒性更换泊沙康唑 | 是 | 否 | 死亡 |
| De Leonardis等[23] |
1 | T-ALL | 诱导化疗 | 不详 | 12/女 | 鼻眶脑 | 两性霉素B脂质体+泊沙康唑 | 是 | 是 | 泊沙康唑维持好转 |
| Mutchnick等[24] | 1 | B-ALL | 诱导化疗 | 不详 | 2/男 | 鼻眶脑 | 两性霉素B+泊沙康唑+米卡芬净 | 是 | 是 | 好转 |
| Abela等25] | 1 | Pre- B-ALL |
造血干细胞移植预处理 | 无 | 5/男 | 鼻眶脑 | 氟康唑 | 是 | 否 | 死亡 |
| 注:ALL为急性淋巴细胞白血病(acute lymphoblastic leukemia); T-ALL为T细胞ALL;B-ALL为B细胞ALL;Pre-B-ALL为前体B细胞ALL。 | ||||||||||
目前,临床上用于治疗毛霉菌病的抗真菌药物主要有两性霉素B及其制剂、艾沙康唑和泊沙康唑等,我国两性霉素B制剂包括:两性霉素B、两性霉素B脂质体、两性霉素B胆固醇硫酸脂复合物。对于鼻眶脑型毛霉病,首选两性霉素B脂质制剂,两性霉素B脂质体中枢神经系统药物的浓度较其他脂质制剂高,且两性霉素B脂质体的不良反应发生率较普通制剂要低。使用两性霉素B脂质体治疗不同器官累及的毛霉菌病,日剂量在1~10 mg/kg,能耐受高剂量治疗的病人往往有更好的反应率。每天接受10 mg/kg两性霉素B脂质体的病人血清肌酐明显升高,但大多数是可逆的,剂量高于10 mg/kg/日不会导致更高的血药浓度[26]。艾沙康唑和泊沙康唑可作为毛霉菌病的挽救治疗药物。毛霉菌治疗失败有两大原因:难治性毛霉菌病或对一线治疗方案的药物不耐受。对于两性霉素B制剂,肾毒性是一个限制因素,如果患者对两性霉素B不耐受,可降低剂量应用,如疾病进展迅速,可考虑加用艾沙康唑或泊沙康唑继续治疗。该患儿为鼻眶脑型毛霉菌病,因其不能耐受大剂量两性霉素B脂质体静脉应用所致的药物肾毒性,除继续静脉应用两性霉素B脂质体及口服泊沙康唑外,考虑给予两性霉素B鞘内注射联合治疗颅内感染。两性霉素B鞘内注射治疗颅内毛霉菌病的相关报道较少,此方案多见于颅内感染隐球菌治疗。本患儿治疗期间给予两性霉素B鞘内注射,初始剂量0.1 mg,逐渐增加至最大1 mg,每周2~3次,期间因患儿头痛、血压升高而降低鞘注剂量。有报道总结,通过两性霉素B与地塞米松混合注射、鞘内注射时反复回抽,从而用自身脑脊液稀释药物、脱水治疗使脑脊液压力下降,再进行注射以及控制单次两性霉素B剂量在0.5 mg以下,是减少两性霉素B鞘内注射不良反应发生的方法[11]。本患儿经过两性霉素B制剂及泊沙康唑治疗鼻眶脑型毛霉菌病,临床表现明显好转,但鼻腔及颅内毛霉菌感染灶消退不明显,最终家属未行手术,签字出院。
3 结论毛霉菌属于条件致病菌,其所致毛霉菌病是一种侵袭性真菌病,多发生于免疫力低下的人群,可引起各种形式的感染,包括皮肤软组织感染、鼻眶脑感染、肺感染、胃肠道感染、播散感染以及其他罕见形式,当其侵及颅内,患者的死亡率大大增加,故早期诊断、早期治疗对于鼻眶脑型毛霉菌病的预后至关重要。恶性血液病合并毛霉菌病的治疗主要包括手术、抗真菌治疗以及控制潜在易感因素。手术治疗和两性霉素B制剂应用是毛霉菌病的一线治疗方法。
| [1] |
Spellberg B, Edwards J Jr, Ibrahim A. Novel perspectives on mucormycosis: pathophysiology, presentation, and management[J]. Clin Microbiol Rev, 2005, 18(3): 556-569.
[DOI]
|
| [2] |
Lersy F, Royer-Leblond J, Lhermitte B, Chammas A, Schneider F, Hansmann Y, Lefebvre N, Denis J, Sabou M, Lafitte F, Cotton F, Boncoeur-Martel MP, Tourdias T, Pruvo JP, Cottier JP, Herbrecht R, Kremer S. Cerebral mucormycosis: neuroimaging findings and histopathological correlation[J]. J Neurol, 2022, 269(3): 1386-1395.
[DOI]
|
| [3] |
Skiada A, Lass-Floerl C, Klimko N, Ibrahim A, Roilides E, Petrikkos G. Challenges in the diagnosis and treatment of mucormycosis[J]. Med Mycol, 2018, 56(suppl_1): 93-101.
[DOI]
|
| [4] |
Talmi YP, Goldschmied-Reouven A, Bakon M, Barshack I, Wolf M, Horowitz Z, Berkowicz M, Keller N, Kronenberg J. Rhino-orbital and rhino-orbito-cerebral mucormycosis[J]. Otolaryngol Head Neck Surg, 2002, 127(1): 22-31.
[DOI]
|
| [5] |
Steinbrink JM, Miceli MH. Mucormycosis[J]. Infect Dis Clin North Am, 2021, 35(2): 435-452.
[DOI]
|
| [6] |
Zhang J, Luo J, Weng X, Zhu Y, Goyal G, Perna F, Espinoza-Gutarra M, Jiang L, Chen L, Mi JQ. A case report of the metagenomics next-generation sequencing for early detection of central nervous system mucormycosis with successful rescue in patient with recurrent chronic lymphocytic leukemia[J]. Ann Transl Med, 2022, 10(12): 722.
[DOI]
|
| [7] |
Pagano L, Dragonetti G, De Carolis E, Veltri G, Del Principe MI, Busca A. Developments in identifying and managing mucormycosis in hematologic cancer patients[J]. Expert Rev Hematol, 2020, 13(8): 895-905.
[DOI]
|
| [8] |
李孟达, 叶俊杰. 鼻-眼-脑型毛霉菌的研究现状[J]. 中华眼科杂志, 2019, 55(8): 629-633. [DOI]
|
| [9] |
Rudramurthy SM, Hoenigl M, Meis JF, Cornely OA, Muthu V, Gangneux JP, Perfect J, Chakrabarti A, ECMM and ISHAM. ECMM/ISHAM recommendations for clinical management of COVID-19 associated mucormycosis in low-and middle-income countries[J]. Mycoses, 2021, 64(9): 1028-1037.
[DOI]
|
| [10] |
郑洪, 时文杰, 邓琦. 急性淋巴细胞白血病并发鼻眶肺毛霉菌病1例[C] //中华医学会呼吸病学年会——2013第十四次全国呼吸病学学术会议论文集. 大连: 中华医学会、中华医学会呼吸病学分会, 2013: 108-109. [URI]
|
| [11] |
高陆, 彭志元, 冯永怀, 袁钟. 泊沙康唑联合两性霉素B脂质体治疗鼻-眼-脑型毛霉菌病1例并文献复习[J]. 中国感染控制杂志, 2021, 20(7): 663-667. [DOI]
|
| [12] |
李文梓, 朱华, 全美洁, 王丽, 温丽, 王嘉敏, 李华利, 赵艳荣, 杨明丽, 孟宪彬. 宏基因组二代测序在儿童急性白血病化疗后合并毛霉菌病早期诊断中的应用价值[J]. 中国小儿血液与肿瘤杂志, 2022, 27(6): 363-366. [DOI]
|
| [13] |
霍春秀, 戎赞华, 窦志艳, 张宝玺, 马夫天, 吴晓莉. 儿童急性T淋巴细胞白血病合并毛霉菌感染1例并文献复习[J]. 临床荟萃, 2018, 33(9): 808-812. [DOI]
|
| [14] |
Damavandi SA, Adib S, Ashayeri N. Brain mucormycosis in a child with acute lymphoblastic leukemia[J]. Radiol Case Rep, 2021, 16(9): 2808-2811.
[DOI]
|
| [15] |
Rincón CCA, Silva-Ramos CR, Arancibia JA, Prada-Avella MC, Suárez A. Rhino-orbito-cerebral mucormycosis in an acute lymphoblastic leukemia pediatric patient. Case report and review of literature[J]. Infez Med, 2022, 30(2): 298-303.
[DOI]
|
| [16] |
Kebudi R, Kızılocak H, Hafız G, Erturan Z. Successful outcome of mucormycosis in a child with acute lymphoblastic leukemia[J]. Turk Pediatri Ars, 2020, 55(2): 207-209.
|
| [17] |
Sharifpour A, Gholinejad-Ghadi N, Ghasemian R, Seifi Z, Aghili SR, Zaboli E, Abdi R, Shokohi T. Voriconazole associated mucormycosis in a patient with relapsed acute lymphoblastic leukemia and hematopoietic stem cell transplant failure: a case report[J]. J Mycol Med, 2018, 28(3): 527-530.
|
| [18] |
Dworsky ZD, Bradley JS, Brigger MT, Pong AL, Kuo DJ. Multimodal treatment of rhinocerebral mucormycosis in a pediatric patient with relapsed Pre-B acute lymphoblastic leukemia[J]. Pediatr Infect Dis J, 2018, 37(6): 555-558.
[DOI]
|
| [19] |
Ojeda-Diezbarroso K, Aguilar-Rascón J, Jiménez-Juárez RN, Moreno-Espinosa S, Reséndiz-Sánchez J, Romero-Zamora JL. Successful posaconazole salvage therapy for rhinocerebral mucormycosis in a child with leukemia. Review of the literature[J]. Rev Iberoam Micol, 2019, 36(3): 160-164.
[DOI]
|
| [20] |
Jensen TSR, Arendrup MC, von Buchvald C, Frandsen TL, Juhler M, Nygaard U. Successful treatment of rhino-orbital-cerebral mucormycosis in a child with leukemia[J]. J Pediatr Hematol Oncol, 2017, 39(4): e211-e215.
[DOI]
|
| [21] |
Barg AA, Malkiel S, Bartuv M, Greenberg G, Toren A, Keller N. Successful treatment of invasive mucormycosis with isavuconazole in pediatric patients[J]. Pediatr Blood Cancer, 2018, 65(10): e27281.
[DOI]
|
| [22] |
Altini C, Niccoli Asabella A, Ferrari C, Rubini D, Dicuonzo F, Rubini G. (18)F-FDG PET/CT contribution to diagnosis and treatment response of rhino-orbital-cerebral mucormycosis[J]. Hell J Nucl Med, 2015, 18(1): 68-70.
[DOI]
|
| [23] |
De Leonardis F, Perillo T, Giudice G, Favia G, Santoro N. Recurrent rhino-ocular-cerebral mucormycosis in a leukemic child: a case report and review of pediatric literature[J]. Pediatr Rep, 2015, 7(3): 5938.
[DOI]
|
| [24] |
Mutchnick S, Soares D, Shkoukani M. To exenterate or not? An unusual case of pediatric rhinocerebral mucormycosis[J]. Int J Pediatr Otorhinolaryngol, 2015, 79(2): 267-270.
[DOI]
|
| [25] |
Abela L, Toelle SP, Hackenberg A, Scheer I, Güngör T, Plecko B. Fatal outcome of rhino-orbital-cerebral mucormycosis due to bilateral internal carotid occlusion in a child after hematopoietic stem cell transplantation[J]. Pediatr Infect Dis J, 2013, 32(10): 1149-1150.
[DOI]
|
| [26] |
Cornely OA, Alastruey-Izquierdo A, Arenz D, Chen SCA, Dannaoui E, Hochhegger B, Hoenigl M, Jensen HE, Lagrou K, Lewis RE, Mellinghoff SC, Mer M, Pana ZD, Seidel D, Sheppard DC, Wahba R, Akova M, Alanio A, Al-Hatmi AMS, Arikan-Akdagli S, Badali H, Ben-Ami R, Bonifaz A, Bretagne S, Castagnola E, Chayakulkeeree M, Colombo AL, Corzo-León DE, Drgona L, Groll AH, Guinea J, Heussel CP, Ibrahim AS, Kanj SS, Klimko N, Lackner M, Lamoth F, Lanternier F, Lass-Floerl C, Lee DG, Lehrnbecher T, Lmimouni BE, Mares M, Maschmeyer G, Meis JF, Meletiadis J, Morrissey CO, Nucci M, Oladele R, Pagano L, Pasqualotto A, Patel A, Racil Z, Richardson M, Roilides E, Ruhnke M, Seyedmousavi S, Sidharthan N, Singh N, Sinko J, Skiada A, Slavin M, Soman R, Spellberg B, Steinbach W, Tan BH, Ullmann AJ, Vehreschild JJ, Vehreschild MJGT, Walsh TJ, White PL, Wiederhold NP, Zaoutis T, Chakrabarti A, Mucormycosis ECMM MSG Global Guideline Writing Group. Global guideline for the diagnosis and management of mucormycosis: an initiative of the European confederation of medical mycology in cooperation with the mycoses study group education and research consortium[J]. Lancet Infect Dis, 2019, 19(12): e405-e421.
[DOI]
|
 2024, Vol. 19
2024, Vol. 19


